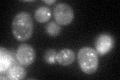
YPL084W
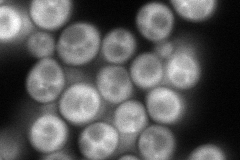
YPL084W
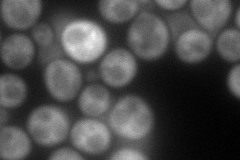
YPL084W
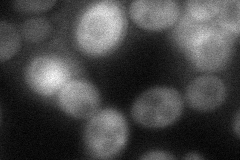
YPL084W

View description
Cytoplasmic class E vacuolar protein sorting (VPS) factor that coordinates deubiquitination in the multivesicular body (MVB) pathway by recruiting Doa4p to endosomes
Localization:
Intensity:
Fold change:
Significance:
-
C’ GFP library in SD
punctate44.07 -
N' NOP1pr-GFP in SD
cytosol,punctate151.266 -
N' TEF2pr-mCherry in SD
cytosol161.26 -
N' NATIVEpr-GFP in SD

punctate32.8744 -
N' TEF2pr-VC and Cyto-VN in SD
cytosol52.6794 -
C’ GFP library in SD+DTT

punctate42.40.96No -
C’ GFP library in SD+H2O2

punctate44.41No -
C’ GFP library in Starvation Media

punctate58.921.33No -
C’ GFP library on the background of Pup2-DaMP

punctate -
C’ GFP library on the background of CCT mutant

punctate40.25050.913186No
